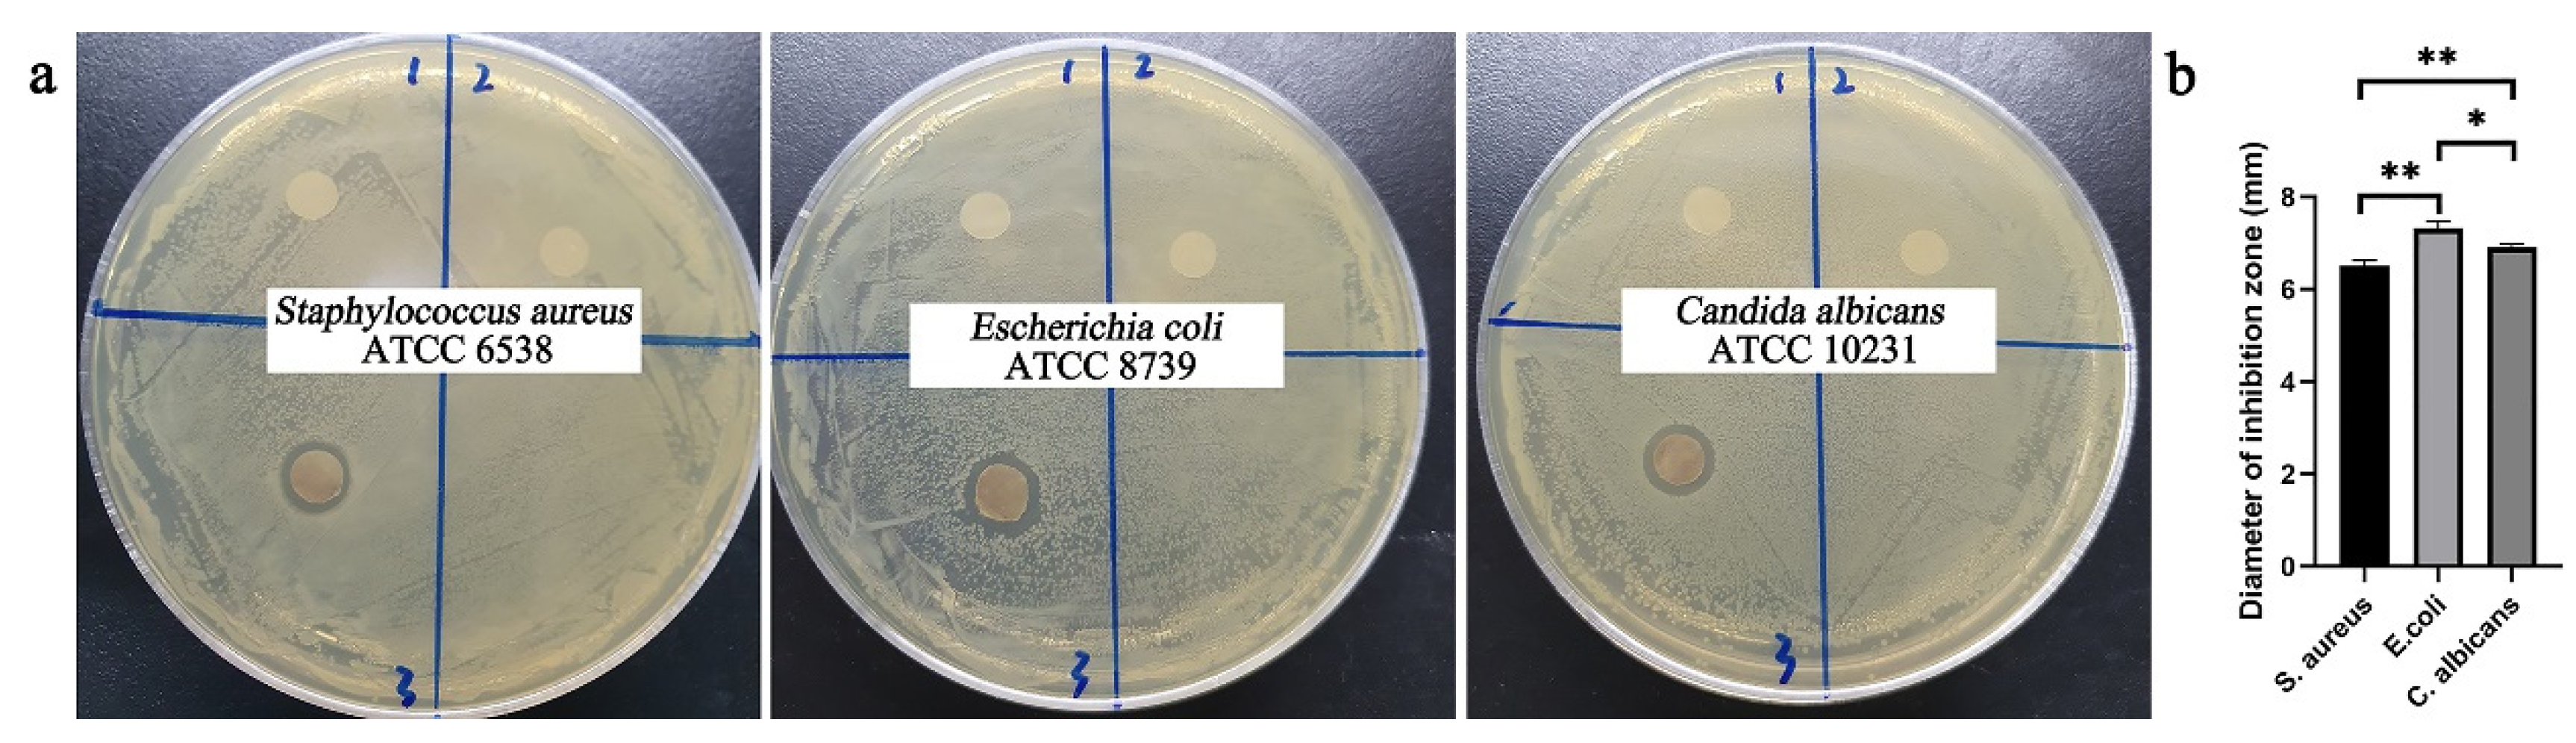
Molecules 26 02783 g008 Molecules 26 02783 g008

Silver Nanoparticle-Anchored Human Hair Kerateine/PEO/PVA Nanofibers for Antibacterial Application and Cell Proliferation
Abstract
1. Introduction
2. Results and Discussion
2.1. Degradation Resistance of AgNP-HHK/PEO/PVA Nanofibers
2.2. Element Distribution of AgNP-HHK/PEO/PVA Nanofibers
2.3. Morphological Properties and Diameter Interpretation
2.4. FTIR Analysis
2.5. XRD Analysis
2.6. Thermal Analysis
2.7. Antibacterial Effect of AgNPs in Nanofibrous Mats
2.8. Cytotoxicity
3. Materials and Methods
3.1. Materials
3.2. Extraction of HHK
3.3. Preparation of Spinning Solution
3.4. Preparation of AgNP-Anchored HHK/PEO/PVA Nanofibers
3.5. In Vitro Degradation of Nanofibers
3.6. Characterizations
3.7. Antibacterial Activity Test
3.8. In Vitro Cytotoxicity Test
3.9. Statistical Analysis
4. Conclusions
Supplementary Materials
Author Contributions
Funding
Institutional Review Board Statement
Informed Consent Statement
Data Availability Statement
Conflicts of Interest
Sample Availability
References
- Fass, D.; Thorpe, C. Chemistry and enzymology of disulfide cross-linking in proteins. Chem. Rev. 2018, 118, 293–322. [Google Scholar] [CrossRef]
- Kornillowicz-Kowalska, T.; Bohacz, J. Biodegradation of keratin waste: Theory and practical aspects. Waste Manag. 2011, 31, 1689–1701. [Google Scholar] [CrossRef]
- Spearman, R.I.C. On the nature of the horny scales of the pangolin. Zool. J. Linn. Soc. Lond. 2010, 46, 267–273. [Google Scholar] [CrossRef]
- Koentjoro, M.P.; Prasetyo, E.N. Advances in use of keratinase from feather wastes for feedstock modification. Appl. Food Biotechnol. 2021, 8, 19–30. [Google Scholar] [CrossRef]
- Silva, R.; Singh, R.; Sarker, B.; Papageorgiou, D.G.; Juhasz, J.A.; Roether, J.A.; Cicha, I.; Kaschta, J.; Schubert, D.W.; Chrissafis, K.; et al. Hybrid hydrogels based on keratin and alginate for tissue engineering. J. Mater. Chem. B 2014, 2, 5441–5451. [Google Scholar] [CrossRef] [PubMed]
- Feroz, S.; Muhammad, N.; Ratnayake, J.; Dias, G. Keratin-Based materials for biomedical applications. Bioact. Mater. 2020, 5, 496–509. [Google Scholar] [CrossRef] [PubMed]
- Sadeghi, S.; Nourmohammadi, J.; Ghaee, A.; Soleimani, N. Carboxymethyl cellulose-human hair keratin hydrogel with controlled clindamycin release as antibacterial wound dressing. Int. J. Biol. Macromol. 2020, 147, 1239–1247. [Google Scholar] [CrossRef] [PubMed]
- Wan, X.Z.; Liu, S.; Xin, X.X.; Li, P.F.; Dou, J.; Han, X.; Kang, I.K.; Yuan, J.; Chi, B.; Shen, J. S-nitrosated keratin composite mats with NO release capacity for wound healing. Chem. Eng. J. 2020, 400, 125964. [Google Scholar] [CrossRef]
- Su, S.; Bedir, T.; Kalkandelen, C.; Basar, A.O.; Sasmazel, H.T.; Ustundag, C.B.; Sengor, M.; Gunduz, O. Coaxial and emulsion electrospinning of extracted hyaluronic acid and keratin based nanofibers for wound healing applications. Eur. Polym. J. 2021, 142, 110158. [Google Scholar] [CrossRef]
- Ponrasu, T.; Veerasubramanian, P.K.; Kannan, R.; Gopika, S.; Suguna, L.; Muthuvijayan, V. Morin incorporated polysaccharide-protein (psyllium-keratin) hydrogel scaffolds accelerate diabetic wound healing in Wistar rats. Rsc Adv. 2018, 8, 2305–2314. [Google Scholar] [CrossRef]
- Lu, T.Y.; Huang, W.C.; Chen, Y.; Baskaran, N.; Yu, J.S.; Wei, Y. Effect of varied hair protein fractions on the gel properties of keratin/chitosan hydrogels for the use in tissue engineering. Colloids Surf. B 2020, 195, 111258. [Google Scholar] [CrossRef]
- Thompson, M.; Giuffre, A.; McClenny, C.; Van Dyke, M. A keratin-based microparticle for cell delivery. J. Biomater. Appl. 2021, 35, 579–591. [Google Scholar] [CrossRef] [PubMed]
- Rajabi, M.; Ali, A.; McConnell, M.; Cabral, J. Keratinous materials: Structures and functions in biomedical applications. Mat. Sci. Eng. C Mater. 2020, 110, 110612. [Google Scholar] [CrossRef] [PubMed]
- Fornasari, B.E.; Carta, G.; Gambarotta, G.; Raimondo, S. Natural-based biomaterials for peripheral nerve injury repair. Front. Bioeng. Biotechnol. 2020, 8, 554257. [Google Scholar] [CrossRef] [PubMed]
- Amaya-Amaya, V.; de Icaza-Herrera, M.; Martinez-Hernandez, A.L.; Martinez-Barrera, G.; Velasco-Santos, C. Experimental approximation of the sound absorption coefficient (proportional to) for 3D printed reentrant auxetic structures of poly lactic acid reinforced with chicken keratin materials. Mater. Lett. 2021, 283, 128757. [Google Scholar] [CrossRef]
- He, M.; Zhang, B.N.; Dou, Y.; Yin, G.Q.; Cui, Y.D.; Chen, X.J. Fabrication and characterization of electrospun feather keratin/poly(vinyl alcohol) composite nanofibers. Rsc Adv. 2017, 7, 9854–9861. [Google Scholar] [CrossRef]
- He, M.; Chen, M.; Dou, Y.; Ding, J.; Yue, H.B.; Yin, G.Q.; Chen, X.J.; Cui, Y.D. Electrospun silver nanoparticles-embedded feather keratin/poly(vinyl alcohol)/poly(ethylene oxide) antibacterial composite nanofibers. Polymers 2020, 12, 305. [Google Scholar] [CrossRef]
- Grkovic, M.; Stojanovic, D.B.; Kojovic, A.; Strnad, S.; Kreze, T.; Aleksic, R.; Uskokovic, P.S. Keratin-polyethylene oxide bio-nanocomposites reinforced with ultrasonically functionalized graphene. Rsc Adv. 2015, 5, 91280–91287. [Google Scholar] [CrossRef]
- Ding, J.; Chen, M.; Chen, W.J.; He, M.; Zhou, X.Y.; Yin, G.Q. Vapor-assisted crosslinking of a FK/PVA/PEO nanofiber membrane. Polymers 2018, 10, 747. [Google Scholar] [CrossRef]
- Hassan, M.A.; Abol-Fotouh, D.; Omer, A.M.; Tamer, T.M.; Abbas, E. Comprehensive insights into microbial keratinases and their implication in various biotechnological and industrial sectors: A review. Int. J. Biol. Macromol. 2020, 154, 567–583. [Google Scholar] [CrossRef]
- Wang, K.; Li, R.; Ma, J.H.; Jian, Y.K.; Che, J.N. Extracting keratin from wool by using l-cysteine. Green Chem. 2016, 18, 476–481. [Google Scholar] [CrossRef]
- Ye, J.; Gong, J.; Su, C.; Liu, Y.; Jiang, M.; Pan, H.; Li, R.; Geng, Y.; Xu, Z.; Shi, J. Fabrication and characterization of high molecular keratin based nanofibrous membranes for wound healing. Colloids Surf. B Biointerfaces 2020, 194, 111158. [Google Scholar] [CrossRef]
- Ham, T.R.; Lee, R.T.; Han, S.; Haque, S.; Vodovotz, Y.; Gu, J.; Burnett, L.R.; Tomblyn, S.; Saul, J.M. Tunable keratin hydrogels for controlled erosion and growth factor delivery. Biomacromolecules 2016, 17, 225–236. [Google Scholar] [CrossRef]
- Yang, G.; Yao, Y.Q.; Wang, X.H. Comparative study of kerateine and keratose based composite nanofibers for biomedical applications. Mat. Sci. Eng. C Mater. 2018, 83, 1–8. [Google Scholar] [CrossRef]
- Saha, S.; Zubair, M.; Khosa, M.A.; Song, S.; Ullah, A. Keratin and chitosan biosorbents for wastewater treatment: A review. J. Polym. Environ. 2019, 27, 1389–1403. [Google Scholar] [CrossRef]
- Ghosh, A.; Collie, S.R. Keratinous materials as novel absorbent systems for toxic pollutants. Def. Sci. J. 2014, 64, 209–221. [Google Scholar] [CrossRef]
- Enkhzaya, S.; Shiomori, K.; Oyuntsetseg, B. Effective adsorption of Au(III) and Cu(II) by chemically treated sheep wool and the binding mechanism. J. Environ. Chem. Eng. 2020, 8, 104021. [Google Scholar] [CrossRef]
- Tehri, N.; Vashishth, A.; Gahlaut, A.; Hooda, V. Biosynthesis, antimicrobial spectra and applications of silver nanoparticles: Current progress and future prospects. Inorg. Nano-Met. Chem. 2020, 2020, 1–19. [Google Scholar] [CrossRef]
- Coriolano, D.D.; de Souza, J.B.; Bueno, E.V.; Medeiros, S.; Cavalcanti, I.D.L.; Cavalcanti, I.M.F. Antibacterial and antibiofilm potential of silver nanoparticles against antibiotic-sensitive and multidrug-resistant Pseudomonas aeruginosa strains. Braz. J. Microbiol. 2020, 52, 267–278. [Google Scholar] [CrossRef] [PubMed]
- Esparza, Y.; Bandara, N.; Ullah, A.; Wu, J.P. Hydrogels from feather keratin show higher viscoelastic properties and cell proliferation than those from hair and wool keratins. Mat. Sci. Eng. C Mater. 2018, 90, 446–453. [Google Scholar] [CrossRef]
- Wu, Z.L.; Abramova, A.; Nikonov, R.; Cravotto, G. Sonozonation (sonication/ozonation) for the degradation of organic contaminants—A review. Ultrason. Sonochem. 2020, 68, 105195. [Google Scholar] [CrossRef] [PubMed]
- Suslick, K.S. Sonochemistry. Science 1990, 247, 1439–1445. [Google Scholar] [CrossRef]
- Cho, D.; Netravali, A.N.; Joo, Y.L. Mechanical properties and biodegradability of electrospun soy protein Isolate/PVA hybrid nanofibers. Polym. Degrad. Stabil. 2012, 97, 747–754. [Google Scholar] [CrossRef]
- Zhou, J.; Cai, D.R.; Xu, Q.B.; Zhang, Y.Y.; Fu, F.Y.; Diao, H.Y.; Liu, X.D. Excellent binding effect of L-methionine for immobilizing silver nanoparticles onto cotton fabrics to improve the antibacterial durability against washing. Rsc Adv. 2018, 8, 24458–24463. [Google Scholar] [CrossRef]
- Pakhomov, P.M.; Ovchinnikov, M.M.; Khizhnyak, S.D.; Lavrienko, M.V.; Nierling, W.; Lechner, M.D. Study of gelation in aqueous solutions of cysteine and silver nitrate. Colloid J. 2004, 66, 65–70. [Google Scholar] [CrossRef]
- Pakiari, A.H.; Jamshidi, Z. Interaction of amino acids with gold and silver clusters. J. Phys. Chem. A 2007, 111, 4391–4396. [Google Scholar] [CrossRef]
- Huang, C.; Liu, Y.; Wu, L.P.; Zhao, H.W. Synthesis of chiral fluorescence silver nano-clusters and study on the aggregation-induced emission enhancement and chiral flip. Rsc Adv. 2016, 6, 105288–105295. [Google Scholar] [CrossRef]
- Jin, S.X.; Xin, B.J.; Zheng, Y.S.; Liu, S.H. Effect of electric field on the directly electrospun nanofiber yarns: Simulation and experimental study. Fibers Polym. 2018, 19, 116–124. [Google Scholar] [CrossRef]
- Kharaghani, D.; Lee, H.; Ishikawa, T.; Nagaishi, T.; Kim, S.H.; Kim, I.S. Comparison of fabrication methods for the effective loading of Ag onto PVA nanofibers. Text. Res. J. 2019, 89, 625–634. [Google Scholar] [CrossRef]
- Liu, H.; Li, D.; Guo, S. Studies on collagen from the skin of channel catfish (Ictalurus punctaus). Food Chem. 2007, 101, 621–625. [Google Scholar] [CrossRef]
- Ullah, A.; Ullah, S.; Khan, M.Q.; Hashmi, M.; Nam, P.D.; Kato, Y.; Tamada, Y.; Kim, I.S. Manuka honey incorporated cellulose acetate nanofibrous mats: Fabrication and in vitro evaluation as a potential wound dressing. Int. J. Biol. Macromol. 2020, 155, 479–489. [Google Scholar] [CrossRef]
- Fan, J.; Lei, T.D.; Li, J.; Zhai, P.Y.; Wang, Y.H.; Cao, F.Y.; Liu, Y. High protein content keratin/poly (ethylene oxide) nanofibers crosslinked in oxygen atmosphere and its cell culture. Mater. Des. 2016, 104, 60–67. [Google Scholar] [CrossRef]
- Zhou, Y.Q.; Wang, J.J.; Yang, G.; Ma, S.Y.; Zhang, M.; Yang, J. Cysteine-rich protein-templated silver nanoclusters as a fluorometric probe for mercury(II) detection. Anal. Methods UK 2019, 11, 733–738. [Google Scholar] [CrossRef]
- Sengwa, R.J.; Choudhary, S. Structural characterization of hydrophilic polymer blends/montmorillonite clay nanocomposites. J. Appl. Polym. Sci. 2014, 131, 40617. [Google Scholar] [CrossRef]
- Choudhary, S. Dielectric dispersion and relaxations in (PVA-PEO)-ZnO polymer nanocomposites. Phys. B 2017, 522, 48–56. [Google Scholar] [CrossRef]
- Deng, L.; Taxipalati, M.; Zhang, A.; Que, F.; Wei, H.; Feng, F.; Zhang, H. Electrospun chitosan/poly(ethylene oxide)/lauric arginate nanofibrous film with enhanced antimicrobial activity. J. Agric. Food Chem. 2018, 66, 6219–6226. [Google Scholar] [CrossRef] [PubMed]
- Vrandecic, N.S.; Erceg, M.; Jakic, M.; Klaric, I. Kinetic analysis of thermal degradation of poly(ethylene glycol) and poly(ethylene oxide)s of different molecular weight. Thermochim. Acta 2010, 498, 71–80. [Google Scholar] [CrossRef]
- Cruz-Maya, I.; Varesano, A.; Vineis, C.; Guarino, V. Comparative study on protein-rich electrospun fibers for in vitro applications. Polymers 2020, 12, 1671. [Google Scholar] [CrossRef] [PubMed]
- Li, S.; Yang, X.H. Fabrication and characterization of electrospun wool keratin/poly(vinyl alcohol) blend nanofibers. Adv. Mater. Sci. Eng. 2014, 2014, 163678. [Google Scholar] [CrossRef]
- Cameron, G.G.; Ingram, M.D.; Qureshi, M.Y.; Gearing, H.M.; Costa, L.; Camino, G. The thermal degradation of poly(ethylene oxide) and its complex with NaCNS. Eur. Polym. J. 1989, 25, 779–784. [Google Scholar] [CrossRef]
- Jiang, D.; Li, J.C.; Wang, S.; Li, H.P.; Qian, L.L.; Li, B.; Cheng, X.X.; Hu, Y.M.; Hu, X. Cyclic compound formation mechanisms during pyrolysis of typical aliphatic acidic amino acids. ACS Sustain. Chem. Eng. 2020, 8, 16968–16978. [Google Scholar] [CrossRef]
- Sharma, R.K.; Chan, W.G.; Seeman, J.I.; Hajaligol, M.R. Formation of low molecular weight heterocycles and polycyclic aromatic compounds (PACs) in the pyrolysis of alpha-amino acids. J. Anal. Appl. Pyrol. 2003, 66, 97–121. [Google Scholar] [CrossRef]
- Ghorbanloo, M.; Fallah, H.N. Silver nanoparticle embedded anionic crosslinked copolymer hydrogels: An efficient catalyst. J. Porous Mater. 2020, 27, 765–777. [Google Scholar] [CrossRef]
- Esparza, Y.; Ullah, A.; Boluk, Y.; Wu, J.P. Preparation and characterization of thermally crosslinked poly(vinyl alcohol)/feather keratin nanofiber scaffolds. Mater. Des. 2017, 133, 1–9. [Google Scholar] [CrossRef]
- Noda, T.; Iwakiri, R.; Fujimoto, K.; Rhoads, C.A.; Aw, T.Y. Exogenous cysteine and cystine promote cell proliferation in CaCo-2 cells. Cell Prolif. 2002, 35, 117–129. [Google Scholar] [CrossRef] [PubMed]

| Element | Atomic Fraction (%) | Atomic Error (%) | Mass Fraction (%) | Mass Error (%) | Fit Error (%) |
|---|---|---|---|---|---|
| C | 90.02 | 3.38 | 79.01 | 1.88 | 0.49 |
| O | 8.17 | 1.67 | 9.55 | 1.93 | 1.73 |
| N | 0.38 | 0.21 | 0.39 | 0.22 | 51.31 |
| S | 0.04 | 0.01 | 0.09 | 0.02 | 4.08 |
| Ag | 1.39 | 0.17 | 10.95 | 1.28 | 0.13 |
| Sample | DSC | TGA | ||||||||||
|---|---|---|---|---|---|---|---|---|---|---|---|---|
| Tm1 /°C | ΔHm1/J·g−1 | Tm2 /°C | ΔHm2/J·g−1 | Tm3 /°C | ΔHm3/J·g−1 | Tm4 /°C | ΔHm4/J·g−1 | Peak1 /°C | Peak2 /°C | Peak3 /°C | Residue at 600 °C/% | |
| a | 47.57 | −52.88 | 195.96 | −621.34 | 339.29 | −3256.72 | 439.06 | −303.48 | 199.70 | 335.00 | 417.72 | 7.31 |
| b | 44.93 | −29.68 | 167.25 | −491.06 | 346.11 | −2909.37 | 481.08 | −2153.35 | 174.84 | 336.32 | 479.54 | 9.01 |
| c | 39.87 | −44.34 | None | None | 343.45 | −2687.29 | 481.39 | −2421.50 | None | 329.39 | 482.18 | 10.52 |
Publisher’s Note: MDPI stays neutral with regard to jurisdictional claims in published maps and institutional affiliations. |
© 2021 by the authors. Licensee MDPI, Basel, Switzerland. This article is an open access article distributed under the terms and conditions of the Creative Commons Attribution (CC BY) license (https://creativecommons.org/licenses/by/4.0/).
Share and Cite
Tang, J.; Liu, X.; Ge, Y.; Wang, F. Silver Nanoparticle-Anchored Human Hair Kerateine/PEO/PVA Nanofibers for Antibacterial Application and Cell Proliferation. Molecules 2021, 26, 2783. https://doi.org/10.3390/molecules26092783
Tang J, Liu X, Ge Y, Wang F. Silver Nanoparticle-Anchored Human Hair Kerateine/PEO/PVA Nanofibers for Antibacterial Application and Cell Proliferation. Molecules. 2021; 26(9):2783. https://doi.org/10.3390/molecules26092783
Chicago/Turabian StyleTang, Jiapeng, Xiwen Liu, Yan Ge, and Fangfang Wang. 2021. "Silver Nanoparticle-Anchored Human Hair Kerateine/PEO/PVA Nanofibers for Antibacterial Application and Cell Proliferation" Molecules 26, no. 9: 2783. https://doi.org/10.3390/molecules26092783
APA StyleTang, J., Liu, X., Ge, Y., & Wang, F. (2021). Silver Nanoparticle-Anchored Human Hair Kerateine/PEO/PVA Nanofibers for Antibacterial Application and Cell Proliferation. Molecules, 26(9), 2783. https://doi.org/10.3390/molecules26092783

